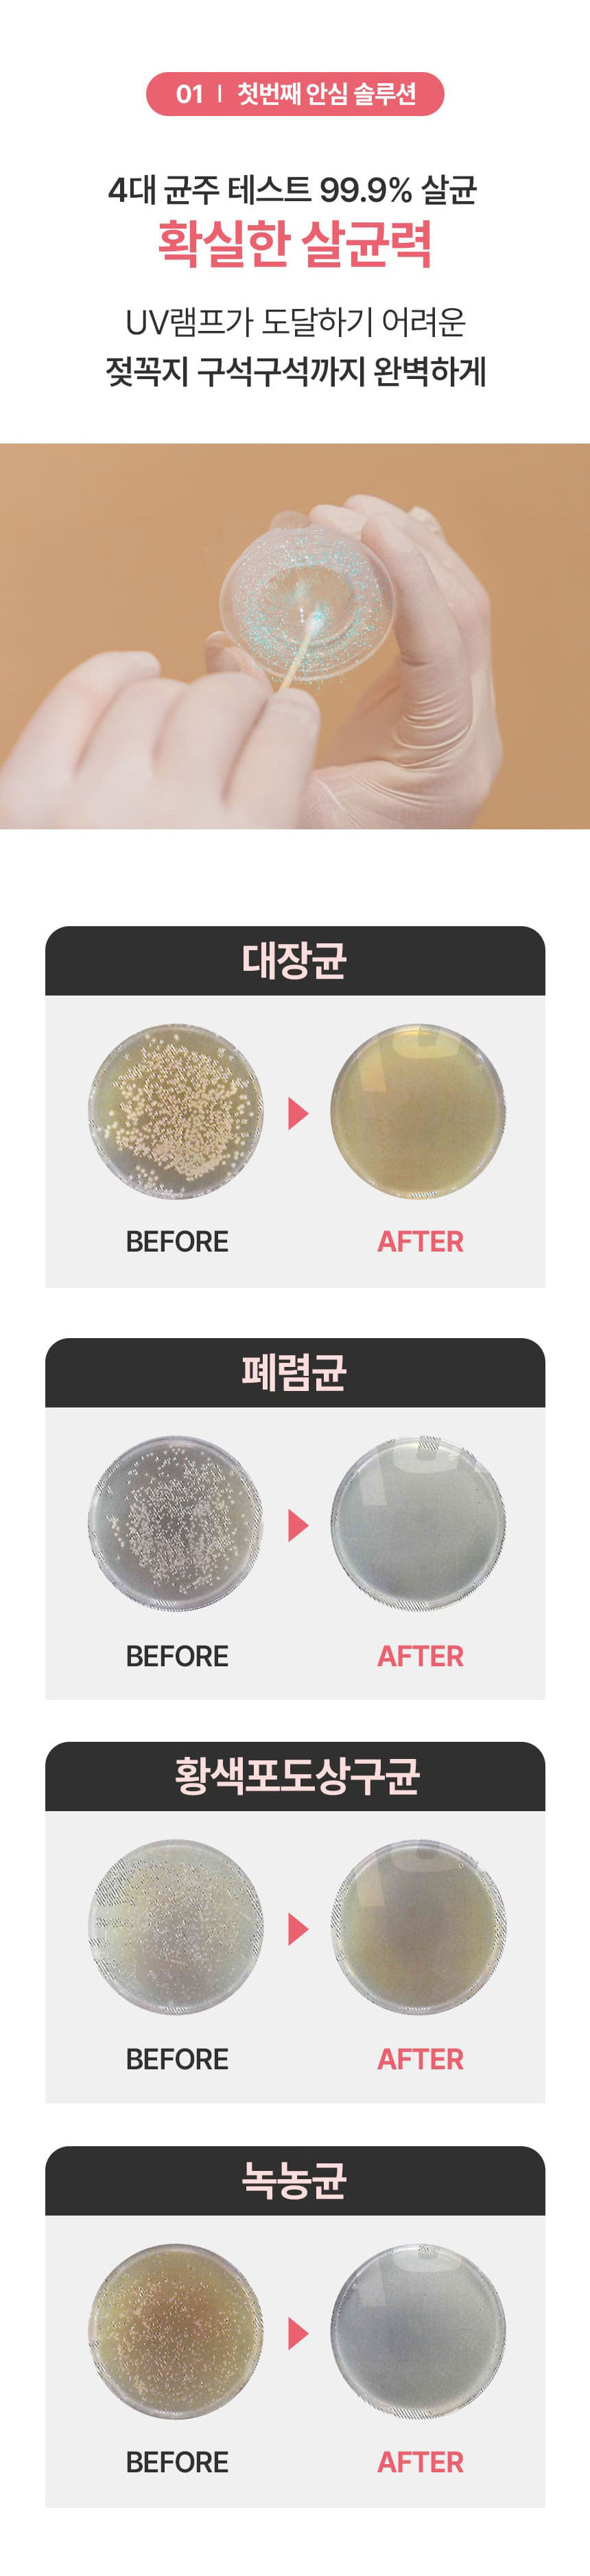
나리몽 UV 젖병소독기

상품 정보 제공고시
- 제품소개
- 상세 페이지 참조
- 색상
- 상세 페이지 참조
- 사이즈
- 상세 페이지 참조
- 제조사
- 상세 페이지 참조
- A/S 책임자와 전화번호
- 상세 페이지 참조
- 제조국
- 중국
- 취급시주의사항
- 상세 페이지 참조
- 품질보증기준
- 상세 페이지 참조
판매자 정보
- 상호명
- 근이통상
- CS 전화번호
- 02-6080-1077
- 대표자
- 문지영
- 사업자등록번호
- 613-34-63000
- 대표 이메일
- keun-2@naver.com
- 통신판매업신고번호
- 2022-서울중구-1802호
- 사업장 소재지
- 서울시 중구 남대문시장6길 19, 제2호(남창동)
배송 정보
- 지정택배사
- CJ대한통운
- 기본배송비
- 무료배송
구매/배송
※ 상품정보에 별도 기재된 경우, 아래의 내용보다 우선하여 적용됩니다.














